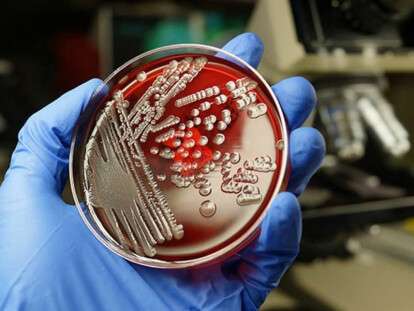
1536267249_palochka

DP-Life

Топ10 рецептов вкусных супов навсегда влюбят в себя тех, кто до этого ненавидел первое (Фото)
"Днепровская панорама" делится рецептами супов. Эти блюда приглянутся даже тем, кто ненавидит первое. Увидев разноплановую подборку из 10 супов, вы навсегда влюбитесь в них и будете их частенько готовить. Солянка сборная мясная ИНГРЕДИЕНТЫ вода 2,5-3 л говядина/телятина или свинина (на…

ТопРестораны Днепра попали в список лучших в мире
Американский журнал Wine Spectator опубликовал мировой рейтинг ресторанов с лучшими винными картами за 2019 год. В список попали 25 украинских ресторана из Киева, Днепра, Одессы, Львова и даже городка Бучи в Киевской области. Издание Wine Spectator разместило три рейтинга за…

ТопКаменских сделала откровенное признание об отношениях с Потапом
Каменских опубликовала трогательное фото, на котором они с Потапом сидят на ступеньках лицом друг к другу. Потап обнимает Настю за плечи. Под фото певица написала откровенное признание в любви своему новоиспеченному мужу. Смотрите также: Трогательная история любви Потапа и Насти:…

ТопДнепрянка 14 лет незаконно получала пенсию умершего отца: что ей за это будет
На Днепротровщине женщина на протяжении 14 лет после смерти отца получала за него пенсию. Об этом корреспонденты "Днепровской панорамы" узнали на сайте 056 57-летняя женщина была опекуном своего недееспособного отца и получала за него пенсию. После его смерти в 2003…
ТопНа Днепре купаться очень опасно: лучше не рисковать
Из 12 официальных пляжей области только один находится в удовлетворительном состоянии. О санитарно-эпидеомилогической картине на десятках неофициальных мест купания страшно и говорить. Такой нерадостной информацией поделилась начальник отдела санэпиднадзора и организации расследования вспышек ГУ Госпродпотребслужбы в Днепропетровской области Неля Полюхович.…

ТопЯд и выбросы в атмосферу: днепрян призывают задуматься (Фото).
Весь мир активно борется с пластиковым загрязнением и Украина тому не исключение. Сегодня, 3 июля в честь международного дня отказа от пластика, города активно подключаются к флешмобу и отказываются от полиэтиленовых пакетов. Корреспонденты "Днепровской панорамы" предлагают задуматься днепрянам, о том…

Комунальні служби Дніпра цілу ніч ліквідовували наслідки негоди. Роботи тривають
У Дніпрі продовжують ліквідувати наслідки негоди, котра вирувала в місті ввечері 2 липня. Шквальний вітер обвалив близько 130 дерев, вивів з ладу загалом десять трамвайних і тролейбусних маршрутів. Пошкоджено також декілька зупинок громадського транспорту. Комунальні служби міста працювали всю ніч.…

ТопБожья коровка села на руку: к чему и что делать
Божья коровка - это мистическое насекомое, с появлением которого связывают начало белой полосы в жизни. Когда божья коровка появляется - это всегда перемены к лучшему и приятные неожиданные сюрпризы. Об этом корреспонденты "Днепровской панорамы" узнали на сайте акценты. Так, если…

ТопЖитель Днепра построит гигантский многоэтажный плот: такого еще не было (Фото)
Днепровский изобретатель и экстремал Игорь Кочет в скором времени собирается построить вместе с единомышленниками гигантский многоэтажный плот, на котором можно было бы разбить палатки и сплавляться по реке. В увлекательное путешествие можно будет отправиться целыми семьями, потому как плот-дом должен…

ТопДенежные магниты: знаки Зодиака, которые притягивают деньги
Гороскоп знаков Зодиака, которые любят деньги и к которым они идут в руки Гороскоп самых везучих знаков Зодиака, которые в силу ряда особенностей привлекают к себе деньги: Весы Весы добиваются богатства благодаря деловому партнерству, выгодным сделкам и контрактам. В преуспевании…

ТопУченые открыли странный вид насекомых, который превращает жертв в "зомби"
В Австралии ученые обнаружили новый необычный вид мух, которых уже прозвали в честь злодея из сериала "Игра Престолов" Короля ночи. Об этом сообщает ВВС. Мухи данного вида получили такое имя потому, что они активны зимой, их спина покрыта шерстью в…

ТопУникальное видео Днепра в 1954 году: в город съезжались со всего СССР (Видео)
На видео прекрасно видно быт и жизнь советских людей в 1954 году. Так же этот год - год Второго всесоюзного съезда советских писателей в Днепре. В 1954 году по проспекту Карла Маркса в доме 55 был открыт крупнейший в Советском…
Узнать все новости https://dnpr.com.ua/full-news/





